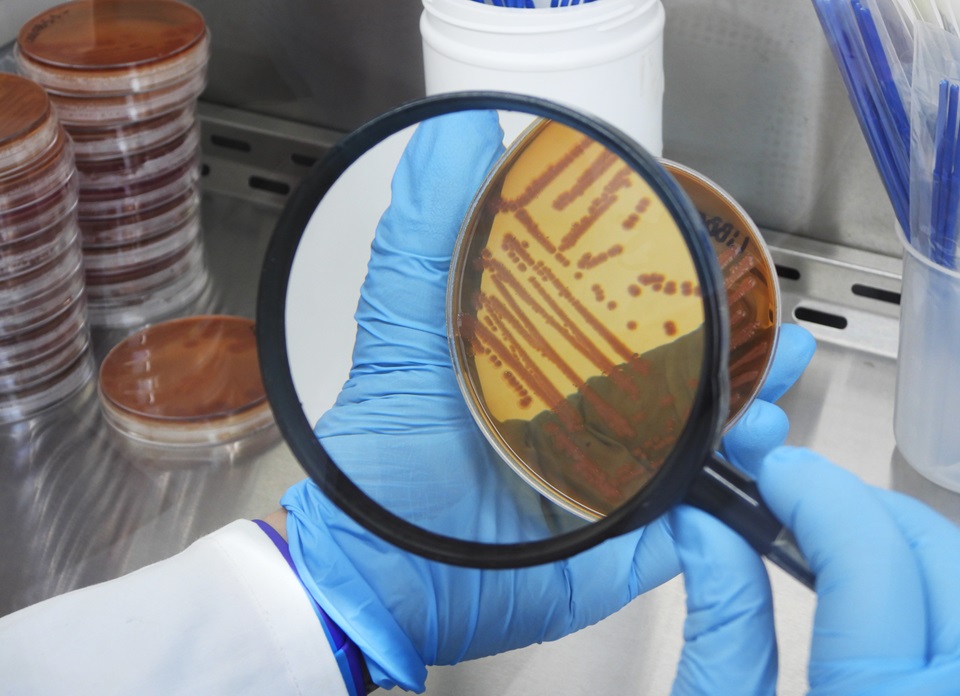
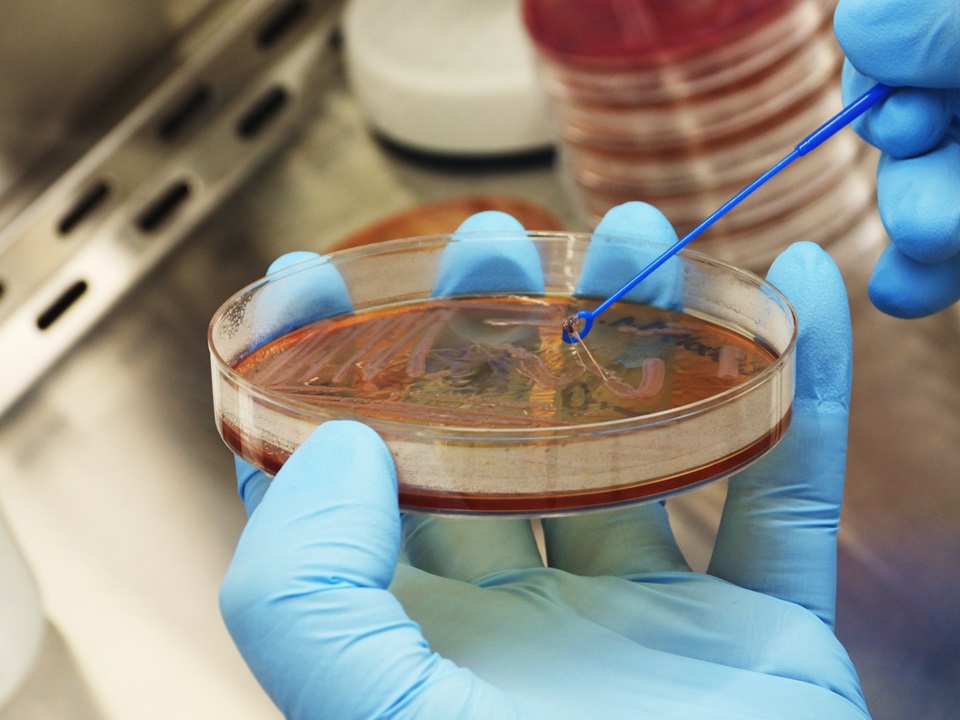

One Health Approach in 2024: Evaluation of antimicrobial resistance in bacterial communities isolated from the skin of small cetaceans that inhabit disturbed coastal areas of Chilean Patagonia.
- Cayetano Espinosa
- Mar 9, 2024
- 2 min read
Updated: Mar 11, 2024
This project is led by Dr. Cayetano Espinosa and is carried out in collaboration with Dr. Pamela Thomson and the Clinical Microbiology and Microbiome Laboratory of the Andrés Bello University, with the financial support of WWF Chile. Researchers from the School of Veterinary Medicine who also participate; Ana Cornejo, José Sepúlveda, Camila del Río, Carolina Sánchez and Carla Simon.
Dr. Cayetano Espinosa & Dr. Pamela Thomson / School of Veterinary Medicine, UNAB.

The skin is a critical interface between an individual and its external environment. In mammals, skin prevents the loss of moisture, regulates body temperature, receives environmental stimuli, reabsorbs lipophilic substances, protects deeper tissues, blocks the entry of pathogens, and synthesizes pre-vitamin D3, which is important for bone formation as well as for the adequate function of brain, heart, muscle and the immune system. The microbiomes of marine mammals are currently underexplored, but recent research shows that generating knowledge on the microbial community composition and the factors that contribute to the variability in the composition among healthy individuals, is an important first step in elucidating the relationship between the skin microbiome and animal health.
At present, the main conservation concern for coastal small cetaceans in Patagonia is the progressive destruction of habitats due to intense aquaculture. Chile is one of the largest producers of farmed salmonids (Salmo salar and Oncorhynchus mykiss) in the world, second only to Norway. Salmon farms are aggregated along the coasts in Patagonia, overlapping the habitat of coastal dolphins. This industry is known to use high concentrations of antibiotics (e.g. 70 to 300 times more than used in Norway).

Hypothesis diagram: Wild fish contaminated with antibiotics are consumed by organisms that are at high trophic levels such as dolphins and humans, which represents a significant risk to public health and animal health.
Aquaculture may increase the risk of infectious diseases in cetaceans by increasing their exposure to bioactive substances (e.g. antibiotics) to the environment. This project is pioneering novel techniques to investigate the effects of human activities on cetaceans, particularly in near‐shore populations that utilise degraded coastal habitats. We are characterizing the composition, diversity and resistance of the skin bacteriomes to understand how anthropogenic stressors affect the health of small cetacean populations.
SPONSORS


If you want to know more about this project, you can contact us through our contact page or write directly to the main researcher (cayetano.espinosa@unab.cl). Follow the project and its progress at @yaqupachachile.

Comments